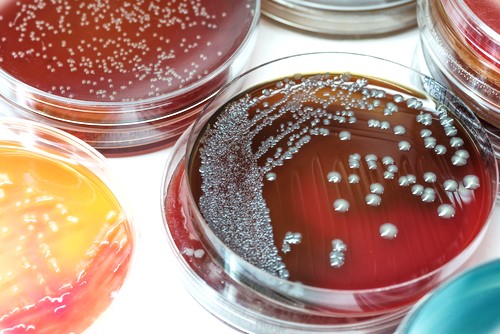
dau-hieu-cum-rubella-ba-bau-la-gi-nhung-bien-chung-co-the-xay-ra 4.jpg

Tốt nghiệp Đại học Y Dược TP. Hồ Chí Minh. Có nhiều năm trong lĩnh vực dược phẩm. Hiện đang là giảng viên cho Dược sĩ tại Nhà thuốc Long Châu.
Dấu hiệu cúm Rubella bà bầu là gì? Những biến chứng có thể xảy ra
Tuyết Vĩ
08/12/2024
Mặc định
Lớn hơn
Bệnh Rubella có khả năng ảnh hưởng nghiêm trọng đến sức khỏe của mẹ bầu và thai nhi, đặc biệt khi nhiễm bệnh trong giai đoạn đầu của thai kỳ. Việc nhận biết sớm dấu hiệu cúm Rubella ở bà bầu là rất quan trọng để có biện pháp xử lý kịp thời.
Phụ nữ mang thai khi mắc bệnh Rubella có thể khiến thai nhi đối mặt với nguy cơ cao bị dị tật bẩm sinh. Do đó, nếu xuất hiện các triệu chứng giống cúm do Rubella gây ra, bà bầu cần đặc biệt chú ý và áp dụng các biện pháp phòng ngừa phù hợp để đảm bảo an toàn cho thai nhi. Vậy, dấu hiệu cúm Rubella ở bà bầu là gì?
Dấu hiệu cúm Rubella ở bà bầu
Rubella, hay còn gọi là bệnh sởi Đức, là một bệnh truyền nhiễm qua đường hô hấp do virus Rubivirus gây ra. Thời gian ủ bệnh thường kéo dài từ 2 đến 3 tuần, sau đó người bệnh sẽ xuất hiện các triệu chứng tương tự như cảm cúm.
Để bảo vệ sức khoẻ cho bà bầu, người bệnh cần lưu ý những dấu hiệu đặc trưng để sớm phát hiện và điều trị kịp thời. Dưới đây là những triệu chứng điển hình của Rubella ở bà bầu:
Sốt: Nhiệt độ cơ thể tăng lên khoảng 38,5°C, thường kéo dài trong vài ngày và giảm sau khi phát ban xuất hiện.
Đau nhức cơ thể: Các triệu chứng bao gồm đau đầu, nhức mỏi cơ hoặc khớp, và cảm giác mệt mỏi toàn thân.
Nổi hạch: Các hạch bạch huyết ở vùng cổ, xương chẩm, khuỷu tay, bẹn,... thường sưng lên, sờ thấy đau nhẹ. Tình trạng nổi hạch thường xuất hiện trước khi phát ban và kéo dài ngay cả sau khi ban biến mất.
Phát ban ngoài da: Phát ban thường khởi phát trên đầu, mặt, sau đó lan khắp cơ thể trong vòng 24 giờ. Nốt ban có kích thước 1 đến 2mm, hình tròn hoặc bầu dục, có thể mọc riêng lẻ hoặc thành từng mảng. Ban Rubella khác với ban sởi ở đặc điểm không mọc theo thứ tự cố định và không để lại vết thâm sau khi lặn. Ban thường kéo dài từ 3 đến 10 ngày tùy trường hợp.

Bên cạnh đó, bà bầu cũng nên chú ý các triệu chứng giống cảm cúm như:
- Chảy nước mũi hoặc nghẹt mũi, kèm theo đau họng và ho.
- Sưng, đỏ hoặc viêm mắt, thường kèm theo chảy nước mắt.
- Đau đầu hoặc cảm giác khó chịu toàn thân.
Ngoài ra, đối với phụ nữ đang trong thai kỳ, nếu thấy xuất hiện các dấu hiệu đặc biệt bất thường như đau đầu dữ dội, đau tai kéo dài, hoặc sốt cao không giảm, bà bầu cần nhanh chóng đến bệnh viện để được thăm khám và điều trị kịp thời. Rubella trong thai kỳ có thể gây ảnh hưởng nghiêm trọng đến sức khỏe của cả mẹ và thai nhi, do đó việc can thiệp y tế sớm là rất cần thiết.
Những biến chứng khi mắc cúm Rubella ở bà bầu
Nếu mẹ bầu nhiễm virus Rubella trong 20 tuần đầu của thai kỳ, nguy cơ gặp phải các biến chứng nghiêm trọng là rất cao, bao gồm:
- Sảy thai: Thai nhi không thể phát triển và mất trước tuần thứ 20.
- Thai chết lưu: Thai nhi mất sau 20 tuần tuổi trong tử cung.
- Sinh non: Thai nhi được sinh ra trước tuần thứ 37 của thai kỳ.
Ngoài ra, nếu virus Rubella truyền từ mẹ sang thai nhi, bé có thể mắc hội chứng Rubella bẩm sinh (CRS). Hội chứng này gây ra các dị tật bẩm sinh nghiêm trọng như:
- Về thị lực: Đục thủy tinh thể hoặc các vấn đề khác về mắt.
- Về tim mạch: Dị tật tim bẩm sinh.
- Về thính giác: Nguy cơ điếc bẩm sinh.
- Về sự phát triển: Trẻ có thể bị nhẹ cân, chậm phát triển thể chất và trí tuệ.
Mức độ nghiêm trọng của các dị tật này phụ thuộc vào giai đoạn thai kỳ khi mẹ nhiễm virus. Nếu nhiễm Rubella trong 12 tuần đầu tiên, nguy cơ trẻ mắc CRS là cao nhất. Sau 20 tuần, nguy cơ này giảm đáng kể, nhưng việc phòng tránh vẫn rất quan trọng để bảo vệ cả mẹ và bé.

Các phương pháp chẩn đoán nhiễm Rubella trong thai kỳ
Để xác định mẹ bầu có bị nhiễm Rubella hay không, các bác sĩ thường áp dụng các xét nghiệm chuyên sâu. Dưới đây là hai phương pháp phổ biến nhất:
Xét nghiệm máu
Xét nghiệm máu là cách chính xác nhất để chẩn đoán nhiễm Rubella khi mang thai. Phương pháp này giúp đánh giá nồng độ hai loại kháng thể quan trọng trong cơ thể là IgG và IgM, từ đó xác định khả năng miễn dịch hoặc tình trạng nhiễm bệnh.
- Kháng thể IgM: Xuất hiện trong giai đoạn đầu nhiễm bệnh, đạt mức cao nhất sau 7 đến 10 ngày kể từ khi triệu chứng khởi phát và giảm dần sau vài tuần. Vì vậy, xét nghiệm máu thường được lặp lại sau 2 đến 3 tuần để kiểm tra mức độ thay đổi của IgM.
- Kháng thể IgG: Xuất hiện sau khi IgM giảm và có thể tồn tại suốt đời, phản ánh khả năng miễn dịch lâu dài.
Kết quả xét nghiệm được diễn giải như sau:
- IgG âm tính (≤ 10 IU/mL): Không có kháng thể IgG, chứng tỏ chưa từng nhiễm Rubella hoặc chưa được tiêm phòng.
- IgG dương tính (≥ 10 IU/mL): Cho thấy đã có miễn dịch nhờ tiêm phòng hoặc từng nhiễm Rubella trước đây.
- IgM âm tính: Ít hoặc không có kháng thể IgM, kèm theo sự tăng nhẹ IgG, biểu hiện nguy cơ tái nhiễm.
- IgM dương tính (≥ 0,3 IU/mL): Kháng thể IgM hiện diện, có thể kèm hoặc không kèm IgG, xác nhận tình trạng nhiễm Rubella gần đây.

Nuôi cấy virus
Ngoài xét nghiệm máu, nuôi cấy virus là một phương pháp chẩn đoán hỗ trợ. Kỹ thuật này sử dụng mẫu dịch từ họng hoặc mũi của người bệnh, được thu thập bằng tăm bông, để kiểm tra sự hiện diện của RNA virus Rubella. Đây là bước xác nhận trực tiếp để đảm bảo độ chính xác trong chẩn đoán.
Những phương pháp này không chỉ giúp xác định mẹ bầu nhiễm Rubella mà còn hỗ trợ bác sĩ đưa ra các biện pháp can thiệp phù hợp, giảm thiểu rủi ro cho thai nhi.
Đặc trưng của dấu hiệu cúm Rubella bà bầu là các triệu chứng như: Sốt, nổi hạch và phát ban ngoài da. Rubella ở bà bầu có thể gây ra nhiều ảnh hưởng nghiêm trọng đến sức khỏe mẹ và bé nếu không được phát hiện và điều trị kịp thời. Việc nắm rõ các triệu chứng, thực hiện các xét nghiệm cần thiết và áp dụng biện pháp phòng ngừa sẽ giúp mẹ bầu bảo vệ thai kỳ an toàn. Nếu có bất kỳ nghi ngờ nào về tình trạng sức khỏe, hãy đến gặp bác sĩ để được tư vấn và điều trị kịp thời.
Một trong những biện pháp phòng ngừa hiệu quả nhất là tiêm vắc xin trước khi mang thai. Việc tiêm phòng trước khi mang thai không chỉ bảo vệ người mẹ khỏi các bệnh nguy hiểm mà còn mang lại miễn dịch thụ động cho trẻ sơ sinh. Trẻ em được thừa hưởng kháng thể từ mẹ sẽ có khả năng chống lại nhiều bệnh lý truyền nhiễm nguy hiểm trong những tháng đầu đời, khi hệ miễn dịch của trẻ chưa hoàn thiện.
Phụ nữ trước khi mang thai cần đảm bảo miễn dịch với các bệnh như thủy đậu, viêm gan B, cúm, sởi – quai bị – Rubella và HPV. Đặc biệt, vắc xin phòng Rubella nên được tiêm ít nhất 3 tháng trước khi mang thai. Khoảng thời gian này giúp cơ thể mẹ sản sinh đủ kháng thể bảo vệ, đồng thời tránh ảnh hưởng đến sự phát triển của thai nhi trong giai đoạn đầu.
Việc chủ động tiêm phòng đầy đủ không chỉ bảo vệ sức khỏe người mẹ mà còn đóng vai trò quan trọng trong việc đảm bảo sự phát triển khỏe mạnh và an toàn của trẻ ngay từ trong bụng mẹ.
Hiện Trung tâm Tiêm chủng Long Châu tự hào là đơn vị tiên phong trong lĩnh vực tiêm chủng với các loại vắc xin thế hệ mới nhất từ các nhà sản xuất hàng đầu thế giới. Tại đây, chúng tôi cam kết mang đến cho khách hàng những sản phẩm an toàn và hiệu quả nhất.
:format(webp)/Left_item_112x150_2_e51d8f7ccb.png)
:format(webp)/Right_item_112x150_3_c1a64920e8.png)
:format(webp)/BG_10_c32ccebc0e.png)
:format(webp)/Bg_Header_LV_2_3_9de228ede3.png)
:format(webp)/Left_item_68x52_3_707c1796e4.png)
:format(webp)/Right_item_68x52_3_90f5a341af.png)
:format(webp)/Duoc_si_nguyen_vu_kieu_ngan_48fc1f2f55.png)